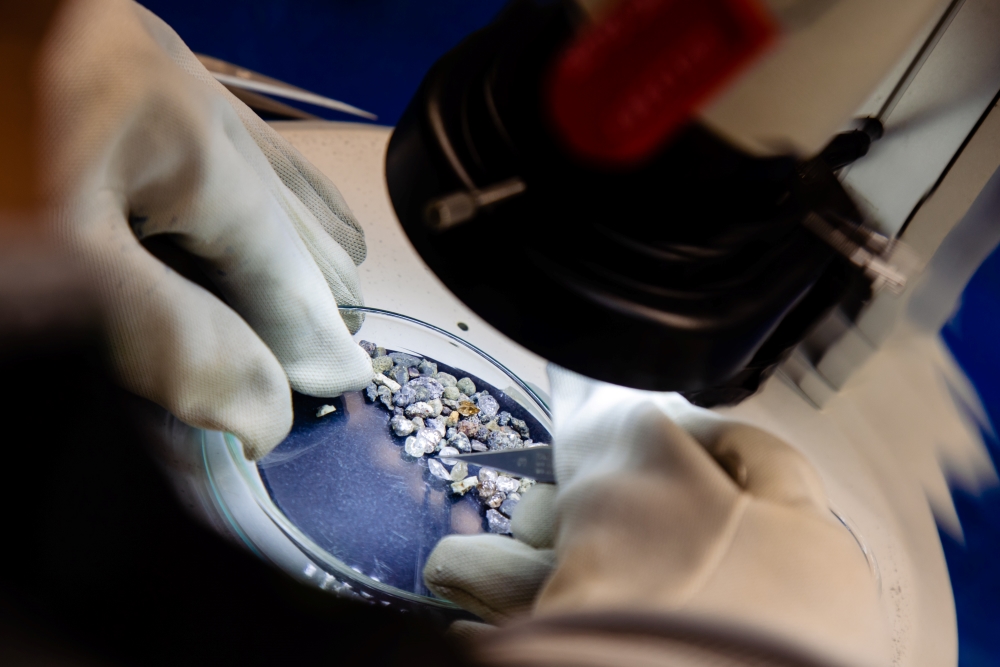

Dr. Lucy Hunt has a keen eye for diamonds. As supervisor of SRC’s Diamond Services group, Dr. Hunt’s knowledge and expertise has helped expand the laboratory’s capabilities.
“Diamonds are a funny commodity,” says Dr. Hunt. “If you have a gold property, you know you have a certain amount of gold, but diamonds are different. They have inclusions or different colours. Some are ugly, industrial diamonds, and some are beautiful diamonds you might wear on a ring.”
SRC’s Diamond Laboratory is one of the world’s largest commercial laboratories, providing industry clients access to a wide range of services. From kimberlite processing to macro and micro diamond recovery, the Diamond Services group offers analysis and processing in a high-security facility that is monitored 24-hours a day.
The lab began operations in the late 1980s, after an unexpected discovery of kimberlites in northern Saskatchewan generated interest in diamond extraction. Kimberlites are volcanic rocks that form from eruptions that originate deep in the earth. Diamonds are pulled into the liquid magma and are carried to the surface, where the kimberlite cools and solidifies.
“Industry thought there might be diamonds in that deposit and came to us for help,” says Dr. Hunt. “We’re always up for a challenge so that’s really where it all started.”
Digging in the lab for diamonds
The Diamond Lab’s recovery services began with caustic fusion — a chemical process that dissolves a kimberlite sample to reveal small diamonds hidden within.
“It’s a job that requires a lot of strength, but also a lot of skill,” says Dr. Hunt. This labour-intensive process takes two days.
First, sodium hydroxide — also known as lye or caustic soda — is added to the kimberlite sample, which is then heated in a kiln. Once complete, a mixture of diamonds and a few other minerals are left behind. This mixture is sieved on a mesh screen, cleaned up in the wet-lab and viewed under a microscope.
From this analysis, clients can use the information SRC provides to decide if their kimberlite sample is promising enough to go ahead with taking bulk samples (or larger volumes) from the site.
The lab runs bigger bulk samples through SRC’s Dense Media Separation (DMS) plant before using X-ray sorting services to analyze the sample’s potential.
DMS uses Ferrosilicon (FeSi) in a water-based slurry to separate materials based on their density. Dense diamonds sink, while lighter minerals rise to the top. At the end of the process, this rich concentrate goes through SRC’s X-ray transmission (XRT) sorter, which recovers diamonds based on their unique carbon composition.
“We have one of the first commercial final recovery XRT machines in the world,” says Dr. Hunt.
After the recovery process is complete, SRC’s Diamond Lab can offer a range of analytical services.
“We’re trying to add more context and more information to a company’s final parcel. It’s not just the number of diamonds, now we can offer other assessments, like diamond typing,” says Dr. Hunt.
Diamonds have several impurities, but nitrogen is one of the most common. Nitrogen-free diamonds – or Type II diamonds – are highly sought after because of their clear, colourless appearance.
Diamonds with nitrogen impurities can appear yellow or even brown.
“We used background from my PhD, where I learned how to use Fourier Transform Infrared Spectroscopy or FTIR, which is a machine that analyzes nitrogen,” says Dr. Hunt. “It’s never really been a commercial instrument, but I wanted to make it available as a service for our clients. That is one of the success stories we have here — now almost every client does FTIR work.”
From academia to industry
“Because of the way secondary school is structured in England, you have to figure out what you want to do at 16, so I thought, ‘I like dinosaurs, I like volcanoes, I’ll be a geologist,’” says Dr. Hunt.
Her undergraduate experience at Durham University (Durham, England) ignited her love of diamonds and led to a Master of Science degree.
“Diamonds are the oldest thing in the world that you will probably ever see — except for a few meteorites,” says Dr. Hunt. “They are from the deepest parts of the earth and are these incredible capsules of information and history.”
Dr. Hunt really wanted to break into the diamond industry and one of her professors suggested she complete a PhD. She applied to the University of Alberta to work under Professor Thomas Stachel, Canadian Research Chair (Tier 1) in Diamonds. Professor Stachel is an expert in inclusions — materials that become trapped in a diamond during its growth.
During her graduate studies, Dr. Hunt worked with diamonds and other indicator minerals from Quebec and Brazil, learning many analytical techniques, from nitrogen analysis to carbon isotopic studies.
“I got to the end of my PhD and decided to stay in academia, so I started a postdoc looking at non-gem diamonds,” she says. “It was an awesome opportunity, but the work wasn’t grabbing me. I just really wanted to do research to help industry.”
When the opportunity to work with industry arose, Dr. Hunt jumped at the chance. She joined SRC’s Advanced Microanalysis Centre™ in 2013, focusing on potash and uranium.
“I was happy to be back to geology doing work that would help a company solve problems or find the next deposit,” she says.
When she moved into the Diamond Lab several years later, Dr. Hunt helped SRC expand their services, setting up diamond breakage and nitrogen assessments.
specialized Diamond Skills, knowledge and expertise
With a passion for diamonds and a wealth of knowledge, Dr. Hunt is equipped with a wide range of skills and unparalleled expertise.
When diamonds are recovered at the lab, they are always evaluated for evidence of damage.
“If it's broken, you can predict how much has been removed and what the size of the diamond would have been if it had remained intact,” says Dr. Hunt.
Since diamonds come in all kinds of shapes and sizes, it takes a lot of experience to accurately assess the damage.
Diamond grading is another process that demands a lot of familiarity with the gemstone, but it’s difficult to gain the right experience.
“You need to have an established reputation in the industry and a price book, which logs years of industry experience and illustrates the change in the market,” says Dr. Hunt. “It’s a lot of information that helps you predict where the markets will go.”
SRC employs a diamond grading expert who has over 20 years of experience, which allows the team to offer clients grading and valuation of their diamond parcels.
“Diamond grading has taken off, but this is certainly an area of growth for the future,” says Dr. Hunt. “We can offer more speculative prices on smaller parcels of diamonds, which otherwise may not have been evaluated.”
Larger parcels are needed to fully evaluate a deposit, but if a value can be given to parcels of diamonds from smaller exploration samples, then it will aid in target prioritization, and help companies make decisions on next steps.
Dr. Hunt loves her role at SRC and is excited to offer clients the information they need to better understand their current and future operations.
“For me, the most amazing thing about this job is that we are the first people in the world to ever see these diamonds,” says Dr. Hunt. “I can look at a diamond and see an inclusion and if, for example, it’s an orange garnet, I know that diamond likely grew about 1.8 billion years ago from a subducted piece of crust.
The surface features and shape of that diamond also tell a story. Understanding diamonds and their properties allows you to read their history like you would read a book, and, ultimately, help industry find new deposits.”
Dr. Hunt and her team are excited to be a part of that story.
Learn more about SRC's diamond services and laboratory.